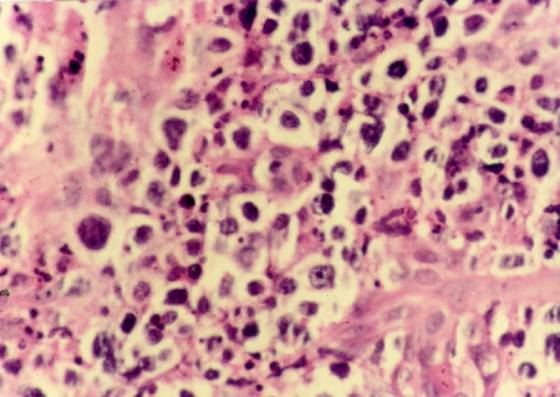

面中线T细胞淋巴瘤(T cell lymphoma, midline of face)
面中线T细胞淋巴瘤(T cell lymphoma, midline of face)是一种特殊类型的T细胞淋巴瘤。
诊断要点:
1. 发生于鼻腔、上呼吸道、肺等处。
2. 浸润性结节、斑块,常有溃疡、坏死。
3. 组织病理示坏死性肉芽肿改变,血管壁受累,免疫病理证实主要为T细胞浸润、增生。
治疗要点:
同皮肤T细胞淋巴瘤。


面中线T细胞淋巴瘤(T cell lymphoma, midline of face)
面中线T细胞淋巴瘤(T cell lymphoma, midline of face)是一种特殊类型的T细胞淋巴瘤。
诊断要点:
1. 发生于鼻腔、上呼吸道、肺等处。
2. 浸润性结节、斑块,常有溃疡、坏死。
3. 组织病理示坏死性肉芽肿改变,血管壁受累,免疫病理证实主要为T细胞浸润、增生。
治疗要点:
同皮肤T细胞淋巴瘤。